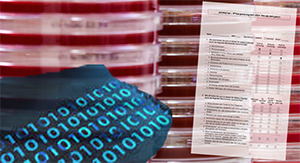

Service Forschung
Unser Service? So individuell wie Ihre Forschung!
Es liegt in der Natur der Sache, dass die IT-Unterstützung für Ihre Forschung nicht nur mit Standardprogrammen und -methoden ablaufen kann. Wir sind deshalb bereit, mit Ihnen gemeinsam Lösungen zu entwickeln für Probleme, die wir alle noch gar nicht kennen.
Fordern Sie uns!